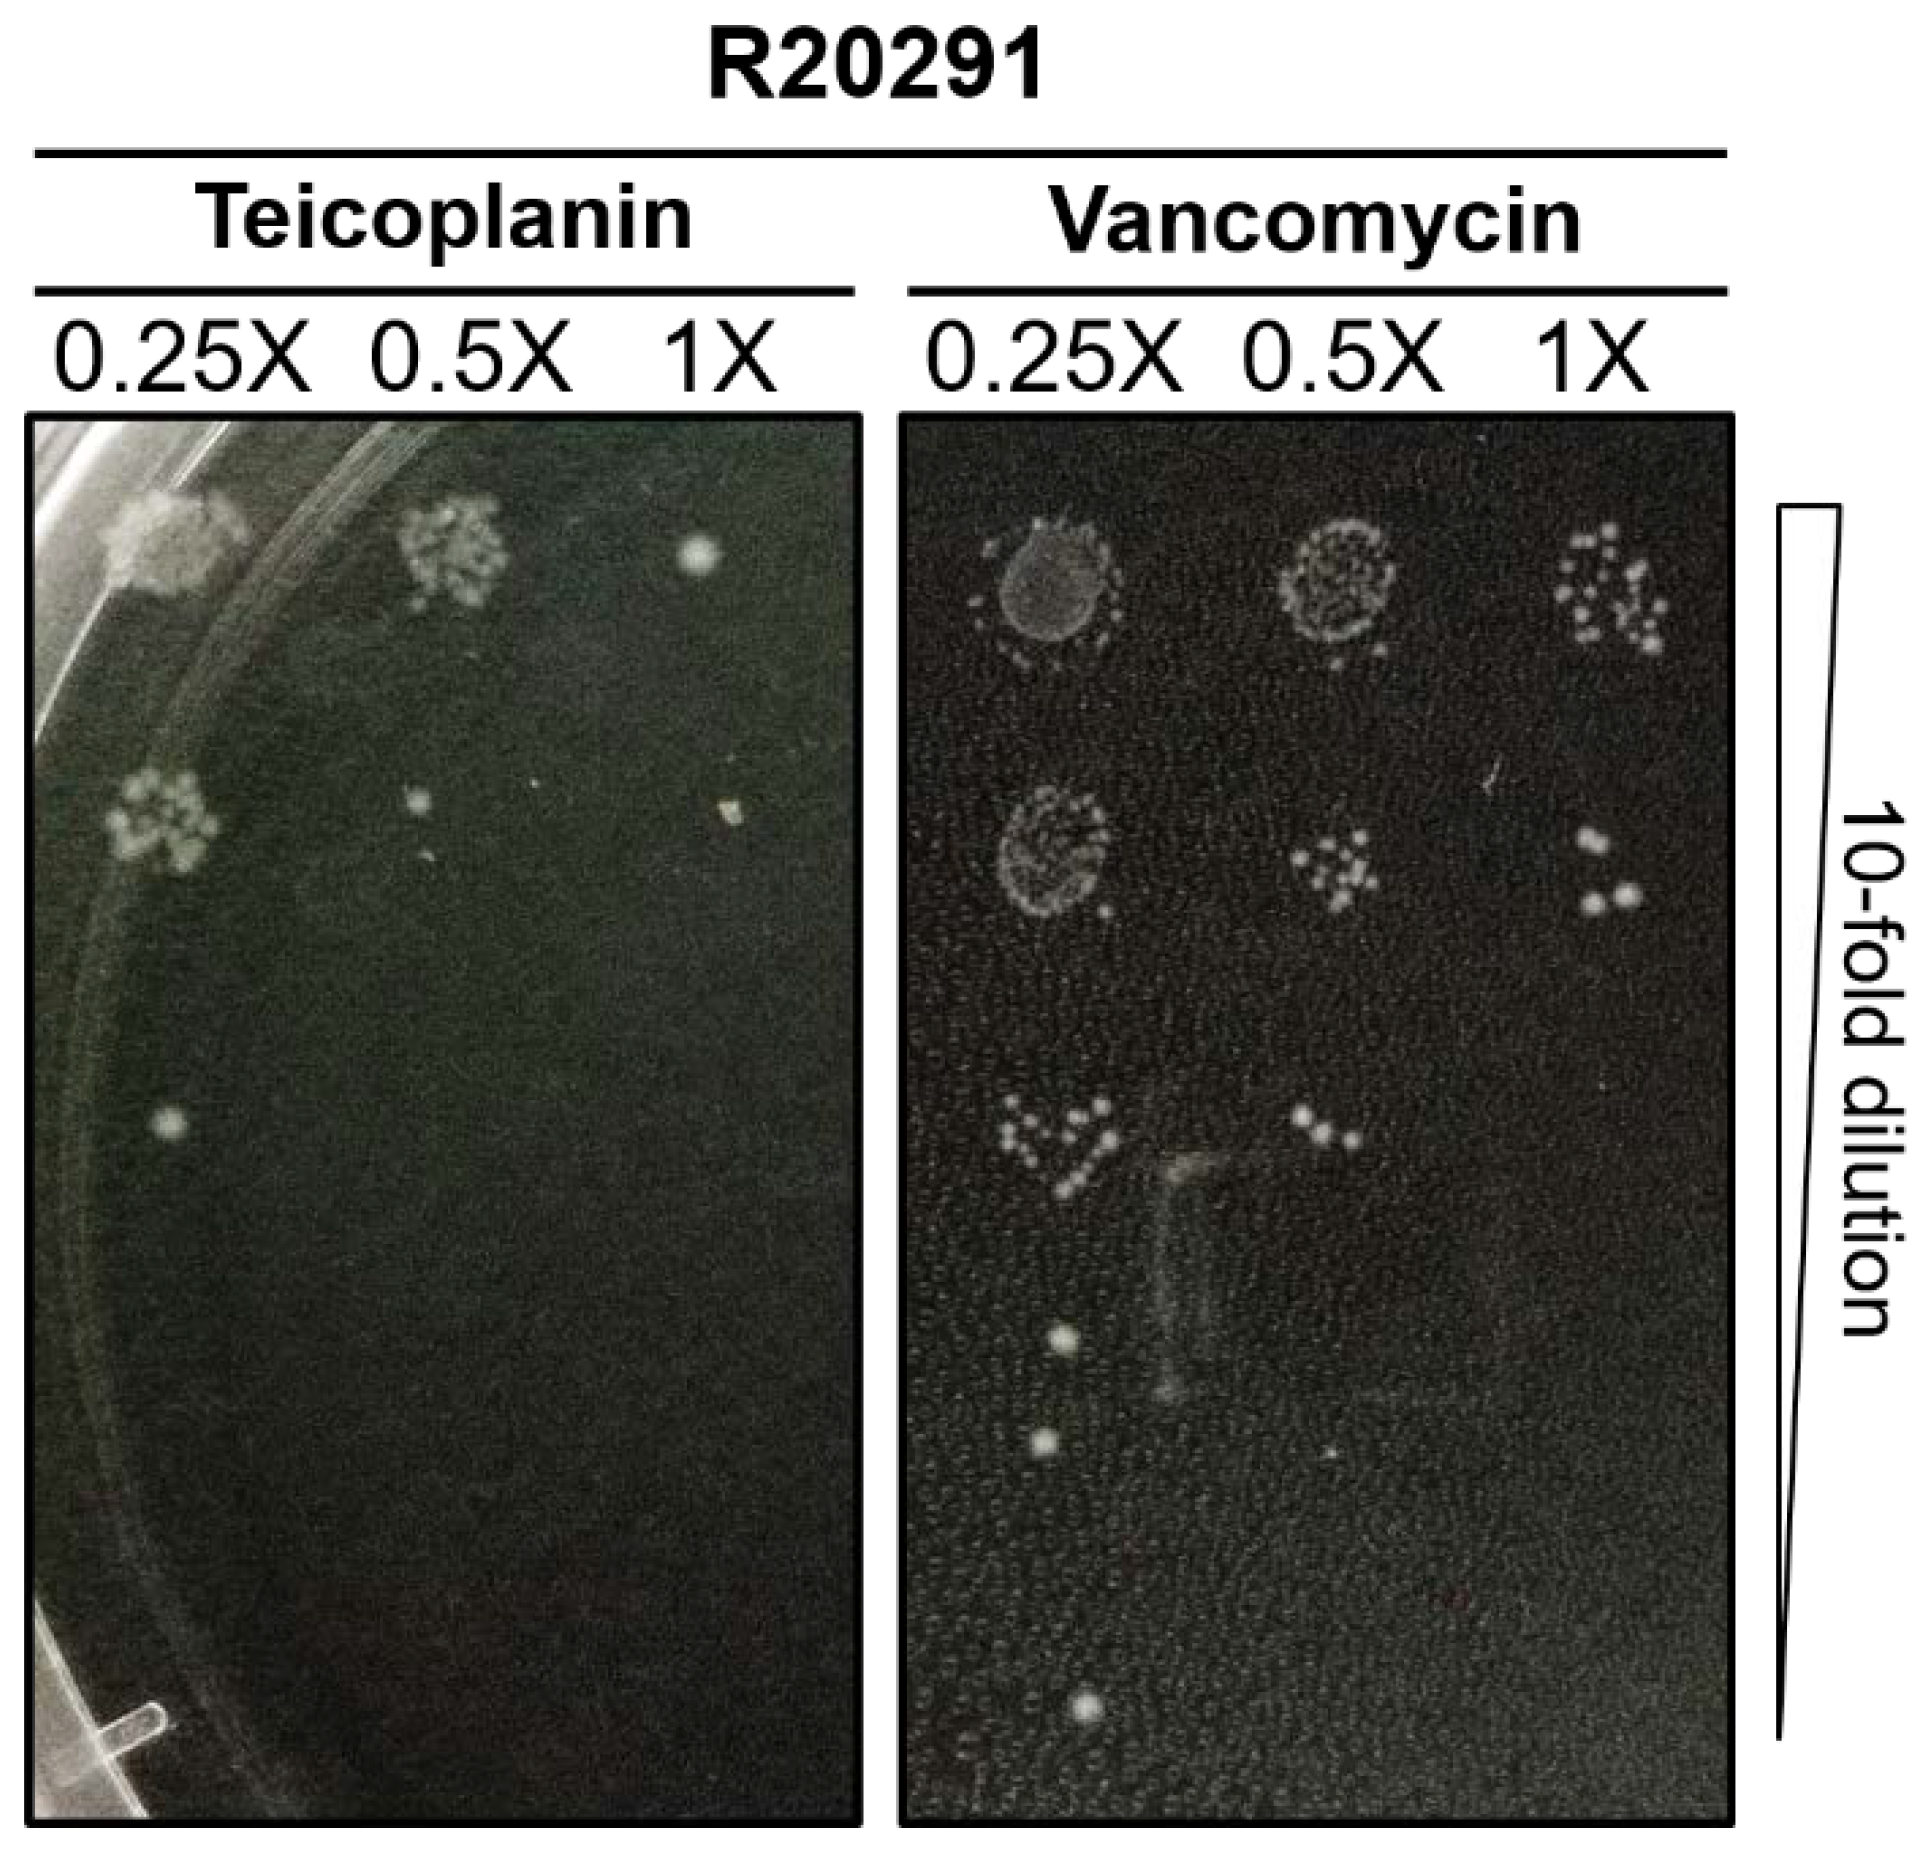
Antibiotics 10 00984 g001 Antibiotics 10 00984 g001

Teicoplanin Suppresses Vegetative Clostridioides difficile and Spore Outgrowth
Abstract
1. Introduction
2. Results
2.1. MICs of Teicoplanin on C. difficile
2.2. Teicoplanin Does Not Inhibit C. difficile Spore Germination
2.3. Teicoplanin Inhibits C. difficile Spore Outgrowth
3. Discussion
4. Materials & Methods
4.1. C. difficile Strains and Growth Conditions
4.2. Spore Preparation
4.3. Antimicrobial Assay
4.4. Spore Germination and Outgrowth
4.5. Wirtz–Conklin Staining
4.6. Statistical Analysis
5. Conclusions
Author Contributions
Funding
Institutional Review Board Statement
Informed Consent Statement
Data Availability Statement
Conflicts of Interest
References
- Ayyagari, A.; Agarwal, J.; Garg, A. Antibiotic-associated diarrhea: Infectious causes. Indian J. Med Microbiol. 2003, 21, 6–11. [Google Scholar]
- Bartlett, J.G. Antibiotic-Associated Diarrhea. N. Engl. J. Med. 2002, 346, 334–339. [Google Scholar] [CrossRef] [PubMed]
- Kelly, C.P.; Pothoulakis, C.; Lamont, J.T. Clostridium difficile Colitis. N. Engl. J. Med. 1994, 330, 257–262. [Google Scholar] [CrossRef] [PubMed]
- King, R.N.; Lager, S.L. Incidence of Clostridium difficile Infections in Patients Receiving Antimicrobial and Acid-Suppression Therapy. Pharmacother. J. Hum. Pharmacol. Drug Ther. 2011, 31, 642–648. [Google Scholar] [CrossRef]
- Seekatz, A.M.; Young, V.B. Clostridium difficile and the microbiota. J. Clin. Investig. 2014, 124, 4182–4189. [Google Scholar] [CrossRef] [PubMed]
- Smits, W.K.; Lyras, D.; Lacy, B.; Wilcox, M.H.; Kuijper, E.J. Clostridium difficile infection. Nat. Rev. Dis. Primers 2016, 2, 1–20. [Google Scholar] [CrossRef]
- Czepiel, J.; Dróżdż, M.; Pituch, H.; Kuijper, E.J.; Perucki, W.; Mielimonka, A.; Goldman, S.; Wultańska, D.; Garlicki, A.; Biesiada, G. Clostridium difficile infection: Review. Eur. J. Clin. Microbiol. Infect. Dis. 2019, 38, 1211–1221. [Google Scholar] [CrossRef]
- Guh, A.Y.; Mu, Y.; Winston, L.G.; Johnston, H.; Olson, D.; Farley, M.M.; Wilson, L.E.; Holzbauer, S.M.; Phipps, E.C.; Dumyati, G.K.; et al. Trends in U.S. Burden of Clostridioides difficile Infection and Outcomes. N. Engl. J. Med. 2020, 382, 1320–1330. [Google Scholar] [CrossRef]
- CDC. Antibiotic Resistance Threats in the United States; CDC: Atlanta, GA, USA, 2019. [Google Scholar]
- McDonald, L.C.; Gerding, D.N.; Johnson, S.; Bakken, J.S.; Carroll, K.C.; Coffin, S.E.; Dubberke, E.R.; Garey, K.W.; Gould, C.V.; Kelly, C.; et al. Clinical Practice Guidelines for Clostridium difficile Infection in Adults and Children: 2017 Update by the Infectious Diseases Society of America (IDSA) and Society for Healthcare Epidemiology of America (SHEA). Clin. Infect. Dis. 2018, 66, e1–e48. [Google Scholar] [CrossRef]
- Musher, D.M.; Aslam, S.; Logan, N.; Nallacheru, S.; Bhaila, I.; Borchert, F.; Hamill, R.J. Relatively Poor Outcome after Treatment of Clostridium difficile Colitis with Metronidazole. Clin. Infect. Dis. 2005, 40, 1586–1590. [Google Scholar] [CrossRef] [PubMed]
- Harnvoravongchai, P.; Pipatthana, M.; Chankhamhaengdecha, S.; Janvilisri, T. Insights into drug resistance mechanisms in Clostridium difficile. Essays Biochem. 2017, 61, 81–88. [Google Scholar] [CrossRef]
- Pushpakom, S.; Iorio, F.; Eyers, P.A.; Escott, K.J.; Hopper, S.; Wells, A.; Doig, A.; Guilliams, T.; Latimer, J.; McNamee, C.; et al. Drug repurposing: Progress, challenges and recommendations. Nat. Rev. Drug Discov. 2019, 18, 41–58. [Google Scholar] [CrossRef]
- Yssel, A.; Vanderleyden, J.; Steenackers, H.P. Repurposing of nucleoside- and nucleobase-derivative drugs as antibiotics and biofilm inhibitors. J. Antimicrob. Chemother. 2017, 72, 2156–2170. [Google Scholar] [CrossRef] [PubMed]
- Reynolds, P.E. Structure, biochemistry and mechanism of action of glycopeptide antibiotics. Eur. J. Clin. Microbiol. Infect. Dis. 1989, 8, 943–950. [Google Scholar] [CrossRef]
- Schaison, G.; Graninger, W.; Bouza, E. Teicoplanin in the Treatment of Serious Infection. J. Chemother. 2000, 12, 26–33. [Google Scholar] [CrossRef]
- de Lalla, F.; Privitera, G.; Rinaldi, E.; Ortisi, G.; Santoro, D.; Rizzardini, G. Treatment of Clostridium difficile-associated disease with teicoplanin. Antimicrob. Agents Chemother. 1989, 33, 1125–1127. [Google Scholar] [CrossRef] [PubMed]
- Pantosti, A.; Luzzi, I.; Cardines, R.; Gianfrilli, P. Comparison of the in vitro activities of teicoplanin and vancomycin against Clostridium difficile and their interactions with cholestyramine. Antimicrob. Agents Chemother. 1985, 28, 847–848. [Google Scholar] [CrossRef]
- Wenisch, C.; Parschalk, B.; Hasenhundl, M.; Hirschl, A.M.; Graninger, W. Comparison of Vancomycin, Teicoplanin, Metronidazole, and Fusidic Acid for the Treatment of Clostridium difficile—Associated Diarrhea. Clin. Infect. Dis. 1996, 22, 813–818. [Google Scholar] [CrossRef] [PubMed]
- Peterson, L.R.; Shanholtzer, C.J. Tests for bactericidal effects of antimicrobial agents: Technical performance and clinical relevance. Clin. Microbiol. Rev. 1992, 5, 420–432. [Google Scholar] [CrossRef] [PubMed]
- Ochsner, U.A.; Bell, S.J.; O’Leary, A.L.; Hoang, T.; Stone, K.C.; Young, C.L.; Critchley, I.A.; Janjic, N. Inhibitory effect of REP3123 on toxin and spore formation in Clostridium difficile, and in vivo efficacy in a hamster gastrointestinal infection model. J. Antimicrob. Chemother. 2009, 63, 964–971. [Google Scholar] [CrossRef] [PubMed]
- Kureishi, A.; Jewesson, P.J.; Rubinger, M.; Cole, C.D.; E Reece, D.; Phillips, G.L.; A Smith, J.; Chow, A.W. Double-blind comparison of teicoplanin versus vancomycin in febrile neutropenic patients receiving concomitant tobramycin and piperacillin: Effect on cyclosporin A-associated nephrotoxicity. Antimicrob. Agents Chemother. 1991, 35, 2246–2252. [Google Scholar] [CrossRef] [PubMed][Green Version]
- Wood, M.J. The comparative efficacy and safety of teicoplanin and vancomycin. J. Antimicrob. Chemother. 1996, 37, 209–222. [Google Scholar] [CrossRef]
- Wilson, A.P.R. Clinical Pharmacokinetics of Teicoplanin. Clin. Pharmacokinet. 2000, 39, 167–183. [Google Scholar] [CrossRef]
- Amidon, S.; Brown, J.E.; Dave, V.S. Colon-Targeted Oral Drug Delivery Systems: Design Trends and Approaches. AAPS PharmSciTech 2015, 16, 731–741. [Google Scholar] [CrossRef]
- Davido, B.; Leplay, C.; Bouchand, F.; Dinh, A.; Villart, M.; Le Quintrec, J.-L.; Teillet, L.; Salomon, J.; Michelon, H. Oral Teicoplanin as an Alternative First-Line Regimen in Clostridium difficile Infection in Elderly Patients: A Case Series. Clin. Drug Investig. 2017, 37, 699–703. [Google Scholar] [CrossRef] [PubMed]
- Kunishima, H.; Saito, M.; Kaku, M.; Chiba, J.; Honda, Y. Antimicrobial susceptibilities of Clostridium difficile isolated in Japan. J. Infect. Chemother. 2013, 19, 360–362. [Google Scholar] [CrossRef]
- Lawler, A.J.; Lambert, P.; Worthington, T. A Revised Understanding of Clostridioides difficile Spore Germination. Trends Microbiol. 2020, 28, 744–752. [Google Scholar] [CrossRef]
- Tocheva, E.I.; López-Garrido, J.; Hughes, H.V.; Fredlund, J.; Kuru, E.; VanNieuwenhze, M.S.; Brun, Y.V.; Pogliano, K.; Jensen, G.J. Peptidoglycan transformations during Bacillus subtilis sporulation. Mol. Microbiol. 2013, 88, 673–686. [Google Scholar] [CrossRef]
- Allen, C.A.; Babakhani, F.; Sears, P.; Nguyen, L.; Sorg, J.A. Both Fidaxomicin and Vancomycin Inhibit Outgrowth of Clostridium difficile Spores. Antimicrob. Agents Chemother. 2013, 57, 664–667. [Google Scholar] [CrossRef] [PubMed]
- de Lalla, F.; Nicolin, R.; Rinaldi, E.; Scarpellini, P.; Rigoli, R.; Manfrin, V.; Tramarin, A. Prospective study of oral teicoplanin versus oral vancomycin for therapy of pseudomembranous colitis and Clostridium difficile-associated diarrhea. Antimicrob. Agents Chemother. 1992, 36, 2192–2196. [Google Scholar] [CrossRef]
- Popovic, N.; Korac, M.; Nesic, Z.; Milosevic, B.; Urosevic, A.; Jevtović, Đ.; Mitrovic, N.; Markovic, A.; Jordovic, J.; Katanic, N.; et al. Oral teicoplanin versus oral vancomycin for the treatment of severe Clostridium difficile infection: A prospective observational study. Eur. J. Clin. Microbiol. Infect. Dis. 2018, 37, 745–754. [Google Scholar] [CrossRef] [PubMed]
- Wu, K.-S.; Syue, L.-S.; Cheng, A.; Yen, T.-Y.; Chen, H.-M.; Chiu, Y.-H.; Hsu, Y.-L.; Chiu, C.-H.; Su, T.-Y.; Tsai, W.-L.; et al. Recommendations and guidelines for the treatment of Clostridioides difficile infection in Taiwan. J. Microbiol. Immunol. Infect. 2020, 53, 191–208. [Google Scholar] [CrossRef] [PubMed]
- Gut, I.M.; Blanke, S.R.; Van Der Donk, W.A. Mechanism of Inhibition of Bacillus anthracis Spore Outgrowth by the Lantibiotic Nisin. ACS Chem. Biol. 2011, 6, 744–752. [Google Scholar] [CrossRef]
- Sun, L.; Atkinson, K.; Zhu, M.; D’Amico, D.J. Antimicrobial effects of a bioactive glycolipid on spore-forming spoilage bacteria in milk. J. Dairy Sci. 2021, 104, 4002–4011. [Google Scholar] [CrossRef]
- Hamouda, T.; Shih, A.Y.; Baker, J.R., Jr. A rapid staining technique for the detection of the initiation of germination of bacterial spores. Lett. Appl. Microbiol. 2002, 34, 5. [Google Scholar] [CrossRef]
- Hamouda, T.; Hayes, M.M.; Cao, Z.; Tonda, R.; Johnson, K.; Wright, D.C.; Brisker, J.; Baker, J.J.R. A Novel Surfactant Nanoemulsion with Broad-Spectrum Sporicidal Activity against Bacillus Species. J. Infect. Dis. 1999, 180, 1939–1949. [Google Scholar] [CrossRef] [PubMed]
- Moir, A.; Lafferty, E.; Smith, D.A. Genetic Analysis of Spore Germination Mutants of Bacillus subtilis 168: The Correlation of Phenotype with Map Location. J. Gen. Microbiol. 1979, 111, 165–180. [Google Scholar] [CrossRef] [PubMed]
- Ojha, S.C.; Chankhamhaengdecha, S.; Singhakaew, S.; Ounjai, P.; Janvilisri, T. Inactivation of Clostridium difficile spores by microwave irradiation. Anaerobe 2016, 38, 14–20. [Google Scholar] [CrossRef]
- Harnvoravongchai, P.; Chankhamhaengdecha, S.; Ounjai, P.; Singhakaew, S.; Boonthaworn, K.; Janvilisri, T. Antimicrobial Effect of Asiatic Acid Against Clostridium difficile Is Associated With Disruption of Membrane Permeability. Front. Microbiol. 2018, 9, 2125. [Google Scholar] [CrossRef]
- Phanchana, M.; Phetruen, T.; Harnvoravongchai, P.; Raksat, P.; Ounjai, P.; Chankhamhaengdecha, S.; Janvilisri, T. Repurposing a platelet aggregation inhibitor ticagrelor as an antimicrobial against Clostridioides difficile. Sci. Rep. 2020, 10, 1–8. [Google Scholar] [CrossRef] [PubMed]
- Koburger, T.; Hubner, N.-O.; Braun, M.; Siebert, J.; Kramer, A. Standardized comparison of antiseptic efficacy of triclosan, PVP-iodine, octenidine dihydrochloride, polyhexanide and chlorhexidine digluconate. J. Antimicrob. Chemother. 2010, 65, 1712–1719. [Google Scholar] [CrossRef] [PubMed]
- Trunet, C.; Carlin, F.; Coroller, L. Investigating germination and outgrowth of bacterial spores at several scales. Trends Food Sci. Technol. 2017, 64, 60–68. [Google Scholar] [CrossRef]

| Strains | Origin | MIC (µg/mL) | |
|---|---|---|---|
| Teicoplanin | Vancomycin | ||
| F101 | Food | 0.06 | 2 |
| F102 | Food | 0.06 | 2 |
| F103 | Food | 0.125 | 2 |
| F104 | Food | 0.125 | 2 |
| A121 | Animal | 0.25 | 4 |
| A122 | Animal | 0.125 | 2 |
| A123 | Animal | 0.25 | 4 |
| A124 | Animal | 0.25 | 4 |
| A125 | Animal | 0.25 | 4 |
| A126 | Animal | 0.125 | 2 |
| R20291 | Human | 0.03 | 0.5 |
| H201 | Human | 0.06 | 1 |
| H203 | Human | 0.125 | 2 |
| H204 | Human | 0.06 | 1 |
| H205 | Human | 0.25 | 4 |
| H206 | Human | 0.25 | 4 |
| H207 | Human | 0.25 | 4 |
| H208 | Human | 0.25 | 4 |
| H209 | Human | 0.125 | 2 |
| H210 | Human | 0.125 | 2 |
| H211 | Human | 0.25 | 4 |
| H212 | Human | 0.125 | 2 |
| H213 | Human | 0.25 | 2 |
| H214 | Human | 0.25 | 4 |
| H215 | Human | 0.25 | 4 |
| H216 | Human | 0.125 | 2 |
| H217 | Human | 0.125 | 2 |
| H218 | Human | 0.25 | 4 |
| 32g57 | Human | 0.125 | 2 |
Publisher’s Note: MDPI stays neutral with regard to jurisdictional claims in published maps and institutional affiliations. |
© 2021 by the authors. Licensee MDPI, Basel, Switzerland. This article is an open access article distributed under the terms and conditions of the Creative Commons Attribution (CC BY) license (https://creativecommons.org/licenses/by/4.0/).
Share and Cite
Ojha, S.C.; Phanchana, M.; Harnvoravongchai, P.; Chankhamhaengdecha, S.; Singhakaew, S.; Ounjai, P.; Janvilisri, T. Teicoplanin Suppresses Vegetative Clostridioides difficile and Spore Outgrowth. Antibiotics 2021, 10, 984. https://doi.org/10.3390/antibiotics10080984
Ojha SC, Phanchana M, Harnvoravongchai P, Chankhamhaengdecha S, Singhakaew S, Ounjai P, Janvilisri T. Teicoplanin Suppresses Vegetative Clostridioides difficile and Spore Outgrowth. Antibiotics. 2021; 10(8):984. https://doi.org/10.3390/antibiotics10080984
Chicago/Turabian StyleOjha, Suvash Chandra, Matthew Phanchana, Phurt Harnvoravongchai, Surang Chankhamhaengdecha, Sombat Singhakaew, Puey Ounjai, and Tavan Janvilisri. 2021. "Teicoplanin Suppresses Vegetative Clostridioides difficile and Spore Outgrowth" Antibiotics 10, no. 8: 984. https://doi.org/10.3390/antibiotics10080984
APA StyleOjha, S. C., Phanchana, M., Harnvoravongchai, P., Chankhamhaengdecha, S., Singhakaew, S., Ounjai, P., & Janvilisri, T. (2021). Teicoplanin Suppresses Vegetative Clostridioides difficile and Spore Outgrowth. Antibiotics, 10(8), 984. https://doi.org/10.3390/antibiotics10080984

